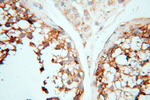
PRR5 Antibody in Immunohistochemistry (Paraffin) (IHC (P))

Search
Proteintech
PRR5 Polyclonal Antibody
{{$productOrderCtrl.translations['antibody.pdp.commerceCard.promotion.promotions']}}
{{$productOrderCtrl.translations['antibody.pdp.commerceCard.promotion.viewpromo']}}
{{$productOrderCtrl.translations['antibody.pdp.commerceCard.promotion.promocode']}}: {{promo.promoCode}} {{promo.promoTitle}} {{promo.promoDescription}}. {{$productOrderCtrl.translations['antibody.pdp.commerceCard.promotion.learnmore']}}
产品信息
17948-1-AP
种属反应
已发表种属
宿主/亚型
分类
类型
抗原
偶联物
形式
浓度
纯化类型
保存液
内含物
保存条件
运输条件
产品详细信息
Immunogen sequence: MAPMPTGQK LLDSLAETWD FFFSDVLPML QAIFYPVQGK EPSVRQLALL HFRNAITLSV KLEDALARAH ARVPPAIVQM LLVLQGVHES RGVTEDYLRL ETLVQKVVSP YLGTYGLHSS EGPFTHSCIL EKRLLRRSRS GDVLAKNPVV RSKSYNTPLL NPVQEHEAEG AAAGGTSIRR HSVSEMTSCP EPQGFSDPPG QGPTGTFRSS PAPHSGPCPS RLYPTTQPPE QGLDPTRSSL PRSSPENLVD QILESVDSDS EGIFIDFGRG RGSGMSDLEG SGGRQSVV (1-287 aa encoded by BC016921)
靶标信息
MARK1 (MAP/microtubule affinity-regulating kinase 1) belongs to the MARK family of serine/threonine kinases. MARK family protein kinases phosphorylate microtubule-associated proteins and may play a role in cytoskeletal stability. MARK2 refers to MAP/microtubule affinity-regulating kinase 2 isoform a [Homo sapiens]. EMK (ELKL Motif Kinase) is a small family of ser/thr protein kinases involved in the control of cell polarity, microtubule stability and cancer. Several cDNA clones have been isolated that encoded two isoforms of the human ser/thr protein kinase EMK1 called MARK2. MARK3 was originally identified as a marker that was induced by treatment with DNA damaging agents, and loss of MARK3 was found with carcinogenesis in the pancreas. MARK4 contains an N terminal serine/threonine kinase domain, a central ubiquitin associated domain, and a C terminal KA1 associated kinase domain. RT PCR analysis detects upregulated expression of the gene for MARK4 in nearly all clinical hepatocellular carcinoma cells.
仅用于科研。不用于诊断过程。未经明确授权不得转售。
生物信息学
蛋白别名: proline rich 5 (renal); Proline-rich protein 5; Protein observed with Rictor-1; Protor-1; prr5; prr5 {ECO:0000250|UniProtKB:P85299}; Rho GTPase activating protein 8; RP1-181C9.3
基因别名: Arhgap8; AU043908; C030017C09Rik; C78947; FLJ20185k; PP610; PROTOR-1; PROTOR1; PRR5
UniProt ID: (Human) P85299, (Rat) Q5FVG6, (Mouse) Q812A5
Entrez Gene ID: (Human) 55615, (Rat) 315189, (Mouse) 109270